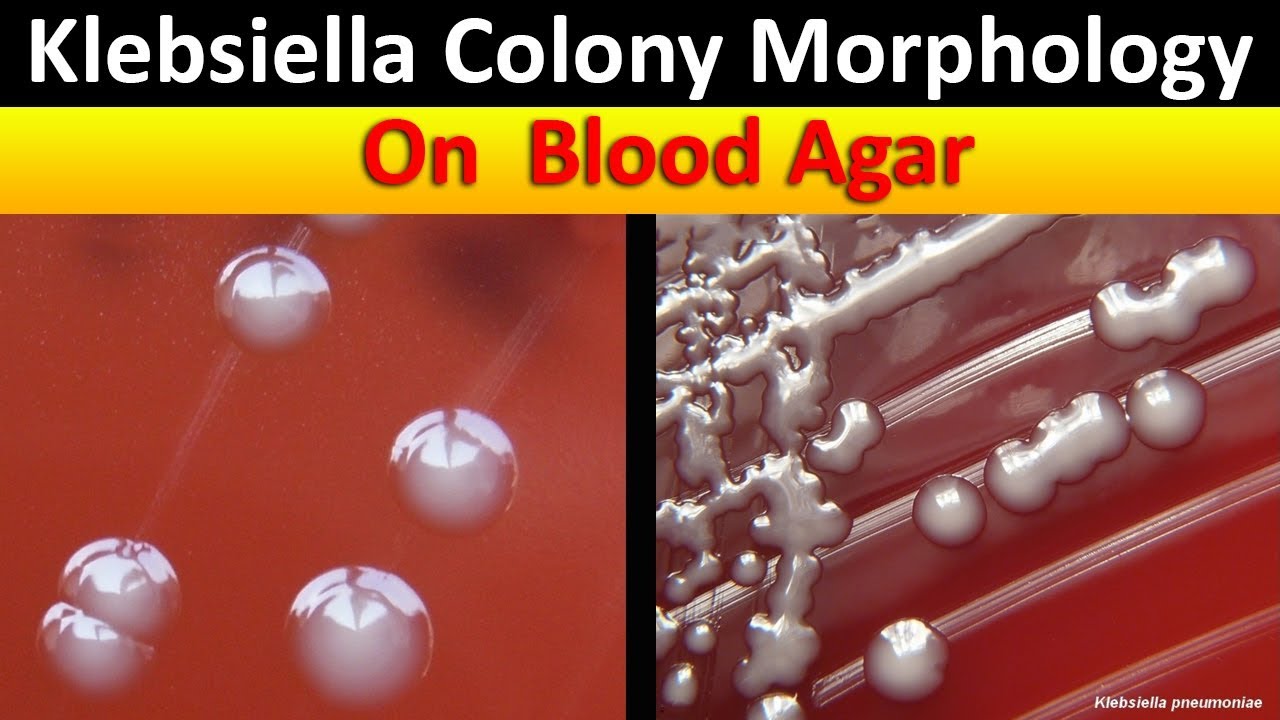
Klebsiella Colony Morphology  On Blood Agar

Culture Characteristic Of Klebsiella скачать в хорошем качестве
Повторяем попытку...

Скачать видео с ютуб по ссылке или смотреть без блокировок на сайте: Culture Characteristic Of Klebsiella в качестве 4k
У нас вы можете посмотреть бесплатно Culture Characteristic Of Klebsiella или скачать в максимальном доступном качестве, видео которое было загружено на ютуб. Для загрузки выберите вариант из формы ниже:
-
Информация по загрузке:
Скачать mp3 с ютуба отдельным файлом. Бесплатный рингтон Culture Characteristic Of Klebsiella в формате MP3:
Если кнопки скачивания не
загрузились
НАЖМИТЕ ЗДЕСЬ или обновите страницу
Если возникают проблемы со скачиванием видео, пожалуйста напишите в поддержку по адресу внизу
страницы.
Спасибо за использование сервиса ClipSaver.ru
Culture Characteristic Of Klebsiella
❇️ Join this channel to get access to perks: / @aladdincreations Hello Viewers !!! My Name Is Kavindu Lakmal , Medical Laboratory Science Student From University Of Peradeniya. I hope this video will helpful for your studies & Knowledge ... Enjoy it ... Don't Forget to subscribe me ... You can update with more new videos .... Please Comment your ideas about Video .... **********************Join With Us ***************************** For More Knowlegeful Videos & Photos ... Like FB Page :- / aladdincreat. . Join Our FB Group :- / 52413. . Follow Us On Instagram :- / laboratory_. . ***************************** HELP ME !!! ********************** I Love to make this like videos Continuously …. But everything need some money , So your little donation I really appreciate . Your just 1$ donation help to design many more videos … Become a Patron - https://www.patreon.com/user?u=4259366 ******************************************************************** Not Only That , Need To Design this Like Video For You Or Any Video Editing Help ??? Contact me ... kavindulakmal478@gmail.com Skype Name - kavindu.lakmal11 Thank You #AladdinCreations #MedicalLaboratoeyScienceVideos #Microbiology #Bacteriology #Micro #Klebsiella #ColonyMorphology #BacteriaColony ******************************************************************** Key Words :- gram negative bacteria,klebsiella pneumoniae,bacteriology,microbiology,microbiology videos youtube,microbiology crash course,aladdin creations,colony morphology,colony morphology of bacteria,Culture Characteristic Of Klebsiella,how to identify klebsiella,How to identify bacteria,klebsiella pneumoniae pronunciation,klebsiella pneumoniae treatment,gram negative bacteria classification,gram negative bacteria microbiology,klebsiella colony morphology